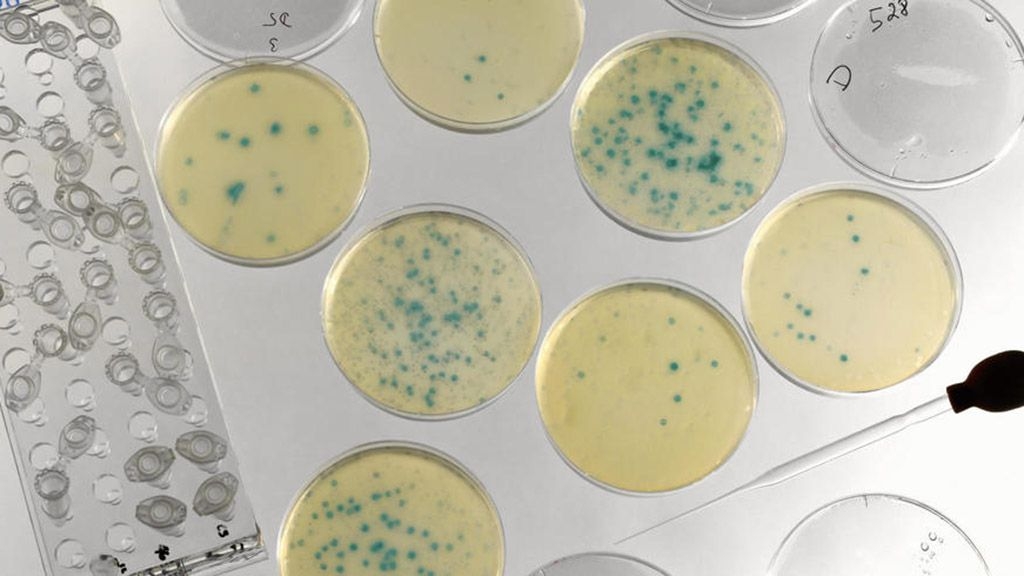
Superbacteris

El mes de novembre del 2015 es va detectar a la Xina, per primer cop, un cep de la bactèria “Eschericia coli” resistent a qualsevol dels antibiòtics coneguts. Aquest mes de maig passat aquest superbacteri ja s’ha trobat als Estats Units i s’hauran de buscar noves fórmules per combatre bacteris que amb poques dècades s’han convertit en resistents a uns medicaments que fins ara semblaven infal·libles.
L’E. coli no és un bacteri difícil de trobar. De fet, tant ocells com mamífers el porten incorporat als seus intestins perquè és necessari per a la correcta digestió dels aliments. “Entèric” és un adjectiu que descriu organismes que viuen en els intestins, i quan sentim a parlar d’enterobacteris o enterovirus a l’aigua, vol dir simplement que aquesta està contaminada per organismes fecals. De mitjana, una persona es treu del damunt cada dia, amb la femta, quasi un bilió de bacteris d’E. coli.
Aquesta facilitat per trobar aquest bacteri i la seva senzilla manipulació al laboratori, fa que sigui un dels que se’n té més coneixement biomolecular i amb el qual s’han fet més experiments.
Què ha fet, doncs, que aquest bacteri s’hagi fet tan resistent als antibiòtics? Primer hem de saber que els antibiòtics són unes substàncies químiques que tenen la capacitat d’inhibir el creixement de microorganismes o d’eliminar-los. “Antibiòtic” ve del grec, de la unió de les paraules “contra” i “vida”. Des de temps remots s’han utilitzat substàncies per al tractament de malalties infeccioses, bàsicament extractes de plantes i fongs. Durant el segle XIX Louis Pasteur va descobrir que alguns bacteris sapròfits –que s’alimenten de restes en descomposició- podien destruir el bacteri de l’àntrax. Però no va ser fins el 1928, quan el britànic Alexander Fleming va descobrir la penicil·lina i els antibiòtics van començar a transformar el món.
Fleming realitzava experiments en el seu laboratori quan, abans de destruir uns cultius de bacteris, va observar que una de les plaques de Petri que tenia sembrades amb “Staphtlococcus aureus” s’havia contaminat amb el fong “Penicillium notatum” i que aquest havia mort tots els bacteris del voltant. El fong produeix una substància natural amb efectes antibacterians a la qual Fleming va batejar com penicil·lina. Tot i que inicialment el descobriment va ser poc valorat, l’arribada de la II Guerra Mundial i la necessitat de curar les infeccions provocades per les ferides, en va disparar l’interès i el seu desenvolupament. La penicil·lina i els seus derivats són dels antibiòtics més coneguts perquè van aconseguir eliminar o reduir significativament moltes malalties, algunes d’elles venèries, que a principis del segle XX estaven molt escampades encara com la sífilis o la gonorrea.
Durant la dècada dels 70 del segle passat els antibiòtics van fer un altre salt amb el descobriment de l’imipenem, que seria l’origen d’aquests medicaments d’ampli espectre. Però la popularització, l’ús i abús dels antibiòtics ha originat problemes nous. Els bacteris han evolucionat i mutat per anar-se fent resistents i la indústria farmacèutica ho ha combatut normalment augmentant la dosi. Però aquest camí és finit. Aquest increment de les dosis no pot ser etern i indiscriminat.
L’excés d’antibiòtics s’elimina a través de l’orina i aquesta acaba anant a la xarxa d’aigües residuals i a les depuradores que tampoc els suprimeixen. Així els rius acaben farcits d’antibiòtics i afectant de retruc les espècies que hi viuen i els aqüífers. Es creu que aquest abocament als rius pot haver contribuït de forma significativa que els bacteris s’hagin fet més resistents. Això implica que aquests medicaments no funcionen bé com abans, o simplement ja no tenen cap efecte curatiu.
L’aparició d’aquest superbacteri de què parlàvem al principi, als EUA s’ha produït en una dona de 49 anys de Pennsilvanià que treballa per al Departament de Defensa. El cep d’aquest bacteri conté un dels gens mòbils que donen resistència a la colistina, l’antibiòtic que s’utilitza com a últim recurs contra els casos més difícils de combatre.
Ens trobem doncs amb un bacteri contra el qual no hi ha, ara per ara, medicament que el pugui combatre. Aquest gen que li dóna aquesta capacitat de resistència a tot és el mcr-1 i va ser trobat per científics britànics i xinesos en un petit grup de persones, carn i animals a la Xina. La sort és que l’E. coli no és dels bacteris més perillosos. El problema és si d’altres amb molta més potencialitat destructiva també adquireixen aquest gen. Llavors ens trobaríem en una situació d’autèntica emergència mundial, quasi impossible de frenar.
De tot això es desprèn la necessitat de moderar el consum d’antibiòtics i d’usar-los només quan siguin estrictament necessaris, tant en persones com en animals. Es calcula que a Europa el mal ús dels antibiòtics mata 25.000 persones cada any.